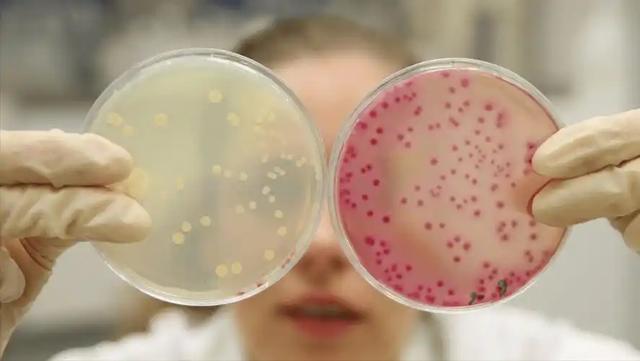

你以为只是“下面不舒服”?可能是霉菌在作怪!很多人误以为是清洁不到位,其实根源远不止于表面。别小看这看似“小毛病”,一拖再拖,反复发作,可能让你陷入“反复治疗-短暂缓解-再次复发”的死循环。
霉菌性阴道炎是个“熟面孔”,尤其在潮湿闷热的季节,它像个不速之客,悄无声息地钻进你的生活。瘙痒是最典型的表现,尤其是晚上,越抓越痒,严重时甚至影响睡眠。
有些人不痒也不痛,但内裤上总是出现一团团像豆腐渣一样的分泌物,别以为是排卵期正常现象,这其实是豆腐渣样白带的典型信号,说明阴道内环境已经被霉菌“霸占”。

除了分泌物异常,有人发现小便时会有灼热感,甚至像针扎一样刺痛,尤其在清洗或性生活后更明显,这说明外阴和阴道黏膜已经被霉菌刺激得不堪重负。
如果你在穿紧身裤或久坐后感到异味明显,别急着喷香氛或用私密护理液掩盖,这种“酸奶味”或“发酵味”其实是霉菌大量繁殖的信号,掩盖只会让它更猖狂。
生活中不是谁都愿意张口说出这个问题,但它的“回头率”之高却令人头皮发麻。复发率高往往和阴道菌群失衡有关,尤其是长期滥用清洁剂或抗生素,容易把“好菌”洗净,留下霉菌独霸一方。

很多人一出现不适就拼命清洗,甚至用醋、盐水泡洗,这种过度清洁反而破坏了阴道自净功能,就像草原被反复踩踏,原本坚韧的生态系统很难恢复。
还有人习惯穿紧身牛仔裤、化纤内裤,尤其是运动后捂得严严实实,湿热环境正是霉菌最喜欢的温床。保持通风干燥的私密环境,比任何药物都更有“预防力”。
饮食习惯也不能忽视。高糖饮食容易让身体处于高糖环境,霉菌偏偏爱吃糖。控制糖分摄入、适量补充益生菌食物,比如酸奶、泡菜、纳豆,有助于调节肠道和阴道的微生态平衡。
有意思的是,心理状态也会“牵一发而动全身”。焦虑、压力大时,免疫力下降,霉菌乘虚而入。所以即使是最好的护理方式,也需要配合稳定的情绪和规律的作息。
在护理上,很多人忽视了月经期的卫生管理。卫生巾长时间不更换,或者使用劣质材质,导致局部潮湿、闷热,是经期感染风险增加的重要原因之一。
如果你是易感人群,比如糖尿病患者、孕妇、长期使用激素药物者,更应关注私密部位的日常护理,避免穿透气性差的衣物,保持私处pH值稳定至关重要。

说到护理,很多人会问能不能用洗液?其实私密处并不需要每日清洗,只要用清水和温和的清洁方式即可,太频繁反而会破坏乳酸杆菌群落,让霉菌趁虚而入。
还有个常被忽略的细节——内裤的材质。建议选择纯棉、颜色浅的内裤,透气性好不刺激皮肤。洗涤时也要注意,避免使用强碱性洗衣粉,中性清洁剂才是更温和的选择。
别搞错了,所谓“治疗六点”不是具体药方,而是生活的点滴细节。第一点是保持日常清洁但不过度;第二点是饮食清淡、减少糖分摄入;第三点是增强免疫力,规律作息、适度运动。
第四点是穿着宽松、透气衣物,避免久坐久捂;第五点是注意经期、孕期、服药期的特殊护理;第六点是定期观察自己身体的变化,发现不适要及时求助医生,避免症状拖延演变成反复。
霉菌性阴道炎并不可怕,但可怕的是忽视它带来的身体信号。每一次发作,都是身体在提醒你:阴道微生态出了问题,需要你用更科学的方式去呵护。
说到底,很多疾病不是突然降临,而是在一次次习惯中悄然生根发芽。就像古人讲“流水不腐,户枢不蠹”,保持身体局部的流通和清洁,才是预防感染的根本。
也别把“霉菌”两个字看得太沉重,它是自然界的一部分,本身并不可怕。真正让它“放肆”的,是你对身体信号的忽视。对抗它,靠的不是恐惧,而是良好的生活习惯。
现代人越来越注重外表打扮,但私密健康却常常被忽略。其实真正的自律,是从关注身体内部开始,从呵护最脆弱的那一部分开始,尊重自己的身体就是最好的自我保护方式。
我们不需要谈“炎”色变,也不该羞于开口。在健康这件事上,沉默从来不是金,而是风险的温床。愿我们都能在日常里多一点觉察,少一次复发。
从“豆腐渣样白带”到“夜间瘙痒难耐”,这些症状不是你一个人在经历。它们像生活中的小石子,虽然不起眼,却可能让你在某天突然“崴脚”。关注私密处的健康,不是小题大做,而是对自己的基本尊重。
霉菌不会因为你“没空理它”就自动消失,它只会在你忽视的时候,悄悄壮大。与其一再回避,不如从今天起,把护理当作日常生活的一部分,建立健康意识才是根本解决之道。
声明:本文为科普内容整理,旨在传播健康知识,内容仅供学习参考,不构成医疗建议或诊断方案,如有症状请尽快前往正规医院就诊。
参考文献:
[1]王洁,张艳.阴道微生态环境与阴道炎关系的研究进展[J].现代妇产科进展,2021,30(7):551-555.[2]刘婷.女性霉菌性阴道炎的预防与护理[J].中国实用护理杂志,2020,36(28):2187-2190.[3]陈琳.女性私密健康管理的现状与建议[J].中国妇幼保健,2022,37(15):3504-3507.
转载请注明来自极限财经,本文标题:《霉菌性阴炎的症状???(发生霉菌性阴道炎)》
京公网安备11000000000001号
京ICP备11000001号
还没有评论,来说两句吧...